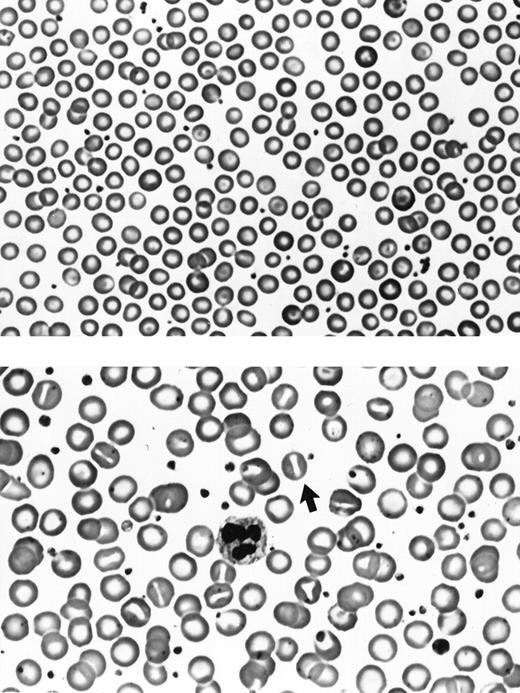
Fig. 3. RBC morphology. (Top) RBCs from a 7.2b knock-out mouse. (Bottom) RBCs from a human hereditary stomatocytosis patient. A typical stomatocyte is indicated by the arrow. Note the absence of stomatocytes in the 7.2b knock-out mouse sample. Original magnification × 500.

Abstract
To examine the relationship between erythrocyte membrane protein 7.2b deficiency and the hemolytic anemia of human hereditary stomatocytosis, we created 7.2b knock-out mice by standard gene targeting approaches. Immunoblots showed that homozygous knock-out mice completely lacked erythrocyte protein 7.2b. Despite the absence of protein 7.2b, there was no hemolytic anemia and mouse red blood cells (RBCs) were normal in morphology, cell indices, hydration status, monovalent cation content, and ability to translocate lipids. The absence of the phenotype of hereditary stomatocytosis implies that protein 7.2b deficiency plays no direct role in the etiology of this disorder and casts doubt on the previously proposed role of this protein as a mediator of cation transport in RBC.
HEREDITARY stomatocytosis is a rare inherited abnormality of human red blood cells (RBCs) that greatly increases permeability to monovalent cations. Because the accumulation of intracellular Na+ exceeds the loss of intracellular K+, there is an increase in intracellular cations accompanied by a movement of water into the cell, cell swelling, a stomatocytic shape change, increased osmotic fragility, and a shortened RBC life span. The result is a moderate to severe lifelong hemolytic anemia.1 The nature of the membrane defect responsible for the strikingly abnormal cation permeability that underlies the disorder is unknown.
Lande, Thiemann, and Mentzer2 were the first to show a deficiency in RBC membrane protein 7.2b in several individuals with hereditary stomatocytosis, a deficiency subsequently found in many,3-5 but not all6 patients with this disorder. This association has given rise to the notion that protein 7.2b, or “stomatin,” as it has come to be known7, is a structural or regulatory component of an ion transport pathway whose function is compromised when protein 7.2b is absent. Proteolytic digestion studies of protein 7.2b, a 31 kD integral membrane polypeptide, which can be palmitylated and exhibits cyclic adenosine monophosphate (cAMP)-dependent phosphorylation,8indicate a very large cytoplasmic tail, but little or no extracellular domain.9 The C-terminus has been localized to the cytoplasmic side of the membrane and the presence of the single phosphorylation site at serine 9 in the N-terminal domain suggests that this end of the molecule is also cytoplasmic.10 These results are compatible with a hairpin-like insertion of the hydrophobic stretch into the bilayer or anchoring through bound lipid.10 The envisioned monotopic insertion into the lipid bilayer has seemed more consistent with a regulatory role than an actual transport channel. The finding that the central portion of a protein (MEC-2) necessary for mechanosensation in Caenorhabditis elegans has considerable homology to human 7.2b (65% identity, 85% similarity) lends support to a channel regulatory role for 7.2b, as MEC-2 appears to function through its linkage of cytoskeletal proteins to degenerin channels.11
The human 7.2b gene consists of seven exons distributed over 40 kb of DNA,12 while the murine protein 7.2b gene is encoded by seven exons spread over about 25 kb of genomic DNA.13 The sequence of human 7.2b cDNA has been reported by several groups and predicts a polypeptide of 287 amino acids consisting of a 24-residue N-terminal sequence, a 29-residue hydrophobic stretch, and a 234-residue C-terminus with a molecular weight of 31,709 kD.5,14 Analysis of cDNA from several protein 7.2b-deficient hereditary stomatocytosis patients has shown no differences from normal.5,15,16 The murine cDNA sequence obtained from C57BL/6J(B6) mice predicts a 7.2b protein of 284 amino acids (four fewer than the human protein) that is 87% identical (and 94% similar) at the amino acid level to the human protein.17 BALB/c mice have a protein 7.2b amino acid sequence that is 98% identical to C57BL/6J, differing in only six amino acids.18 The striking homology between human and murine RBC protein 7.2b provided a way for us to explore the hypothetical cause and effect relationship between 7.2b deficiency and stomatocytosis by creating knock-out mice that totally lack 7.2b and then defining their RBC phenotype. As described in this report, we found that such mice had normal RBCs and did not exhibit the hereditary stomatocytosis phenotype, suggesting that protein 7.2b plays no direct role in the etiology of this disorder and casting doubt on its putative role in regulating ion transport in RBCs.
MATERIALS AND METHODS
Construction of 7.2b Targeting Vector
The vector, pPN2T,19 was modified by cloning the human growth hormone gene-N (hGH-N) polyA-signal/terminator (bp 39 to 622 3′ of the hGH-N translation stop codon) in between the PGKneo and PGKtk cassettes. The hGH-N polyA-signal/terminator20 was inserted in reverse transcriptional orientation with respect to the direction of transcription of the PGK cassettes in pPN2T. The resulting vector, pPN2T-hGHterm, was used as a backbone for the construction of the 7.2b targeting vector. A P1 clone containing the entire murine 7.2b gene (129 strain)13 served as a template for generating the two 7.2b gene fragments that were included in the final targeting vector. First a 1.5-kb polymerase chain reaction (PCR)-generated fragment extending 5′ from nucleotide −527, (counting from the 7.2b transcription start site)13 was inserted between the hGH-N polyA-signal/terminator and the double PGKtk cassettes of pPN2T-hGHterm. A 9.3-kb PCR-generated fragment extending 3′ from nucleotide +110 (counting from the 7.2b transcription start site) was then inserted on the PGK promoter side of the PGKneo cassette to generate the final 21-kb targeting vector, pPN2T-hGHterm-7.2bKO. The composition of the 7.2b knock-out vector is shown in Fig 1.
Generation of Gene Targeted ES Cell Clones and Chimeric Mice
R1 ES cells21 were electroporated with linearized pPN2T-hGHterm-7.2bKO and subjected to G418 (175 μg/mL) fialuridine (FIAU) (0.5 μmol/L) selection for 11 days. ES cell colonies were screened for the targeting event by PCR using a forward primer (7.2b KO-3) not contained in the targeting vector (lies in genomic sequence just 5′ of the 1.5-kb region of homology) and a reverse primer (7.2b KO-4) located within the hGH-N polyA-signal/terminator fragment. 7.2b KO-3 primer: 5′-GAATGTGTGTGAAAGTCAAAATTTG-3′. 7.2b KO-4 primer: 5′-ACCCCATAATATTATAGAAGGACACC-3′. PCR product size: 1.6-kb. PCR conditions: 10 mmol/L Tris (pH 8.0), 50 mmol/L KCl, 1.5 mmol/L MgCl2, 0.001% gelatin, 0.5 μmol/L each primer, 200 μmol/L each deoxynucleotide triphosphate (dNTP), 1 U Taq polymerase, 20 μL reaction volume, 35 cycles at 96°C (20 seconds), 58°C (20 seconds), 72°C (1 minute). Targeting in PCR positive clones was confirmed by probing Southern blots (BamHI cut genomic DNA) with probe A, a 217-bp PCR-generated subfragment of the 1.5-kb region of homology included in the targeting vector. Primers for probe A: A1: 5′-CTATGGGCAAGTGAAAGTC-3′; A2: 5′-TCGTGCTCCTGAACTGAA-3′. PCR conditions: same as for 7.2bK03/4 PCR except extension time at 72°C was 30 seconds. Correctly targeted ES cell clones were used to generate chimeric mice using standard procedures.22 One chimeric male was able to pass the targeted allele through the germline and was bred with 129/SvEv females (Taconic Inc, Germantown, NY) to create mice heterozygous for the targeted allele on the 129 inbred background. These heterozygotes were intercrossed to produce the wild-type, heterozygote, and homozygote littermates used in this study.
Genotyping of Wild-Type, Heterozygous, and Homozygous 7.2b Knock-out Mice
Genotyping of mice was performed by Southern blot analysis using probe A or by using the following three primer PCR screening scheme. Primers: 7.2KO-8: 5′-GTGGATAATACAAACTTCACGAGG-3′ (located at the 3′ side of the 1.5-kb region of homology); 7.2K0-10: 5′-AATGGAGGAGAAGACACGC-3′ (located within the 637 bp region deleted by the targeting event); PGK-T.rev: 5′-CATAGCCTGAAGAACGAGATC-3′ (located in the PGK polyA-signal/terminator portion of the PGKneo cassette). PCR conditions: 0.5 μmol/L primer 7.2KO-8, 0.25 μmol/L primer 7.2bKO-10, 0.25 μmol/L primer PGK-T.rev, 200 μmol/L each dNTP, 1 U Taq polymerase, 20 μL reaction volume, 35 cycles at 96°C (10 seconds), 58°C (10 seconds), 72°C (30 seconds). Under these PCR conditions, PCR product sizes are 506 bp for 7.2KO-8—7.2KO-10 and 740 bp for 7.2KO-8—PGK-T.rev. PCR product sizes for the three different genotypes are as follows: a single product of 506 bp for wild-type, two products of 740 bp and 506 bp for heterozygotes, and a single product of 740 bp for homozygotes.
Determination of the RBC Phenotype
Blood from adult mice was collected in EDTA-coated blood collection tubes.
Western blots.
The absence of protein 7.2b in 7.2b knock-out mouse RBCs was verified by immunoblotting of RBC membrane proteins after separation by sodium dodecyl sulfate (SDS) PAGE on 5% to 15% gels.23 The two anti-7.2b antibodies used were an affinity-purified rabbit polyclonal antihuman 7.2b antibody (kindly provided by Dr Robert Johnson, Department of Biochemistry, Wayne State School of Medicine, Detroit, MI)8 and a murine monoclonal antimouse 7.2b antibody that reacted with the cytoplasmic region of 7.2b (kindly provided by Dr Gary Lewin, Max Delbrueck Centrum for Molecular Medicine, Berlin, Germany).
Hematology.
RBC indices and reticulocyte percentage were determined with an automated hematology analyzer (H*3 System, Bayer Diagnostics, Tarrytown, NY), using a 330 mOsm buffer standardized for mouse RBC, and the hematocrit was measured by centrifugation.24
Osmotic gradient ektacytometry.
Intact RBCs were studied using osmotic gradient ektacytometry, in which RBC deformation is measured as a function of osmolality of the suspending medium.24 25 For each sample, the degree of maximal deformability (DImax), the hypotonic osmolality at which minimal deformability is found (Omin), and hypertonic osmolality (Ohyp) at which DI = 1/2*DImax was recorded.
Intracellular Na and K concentrations.
Phosphatidyl serine exposure.
Phospholipid asymmetry is well maintained in the normal RBC, and phosphatidyl serine (PS) is located exclusively on the inside of the membrane lipid bilayer. The exposure of PS on the surface of RBCs was measured using fluorescent Annexin V.28 RBCs were suspended in buffer to a final concentration of 4 × 106cells/mL, and 4 μL of a 500-μmol/L fluorescein isothiocyanate (FITC)-labeled annexin V solution was added to 0.5 mL of this suspension in the presence of 2 mmol/L Ca2+. The samples were incubated for 30 minutes at room temperature and subsequently washed with buffer to remove unbound annexin. The labeled cells were resuspended to approximately 106 cells per 250 μL in buffer for flow cytometric analysis on a Becton Dickinson FACScan flow cytometer (Becton Dickinson, San Jose, CA). Calcium and ionophore treatment will induce membrane lipid scrambling and exposure of PS on the surface of RBCs.28 RBCs at a 16% hematocrit were equilibrated in incubation buffer with 1 mmol/L calcium for three minutes at 37°C. Subsequently, calcium ionophore A23187 was added to the RBC suspension to a final concentration of 4 μmol/L. The process was stopped by a wash with 5 mmol/L EDTA to remove calcium. Subsequently, the cells were washed in buffer containing 1% bovine serum albumin (BSA) to remove the ionophore and resuspended in buffer without BSA. Calcium-treated cells were used as controls for PS exposing RBCs.
RESULTS
Disruption of the 7.2b Gene by Gene Targeting
As shown in Fig 1A, exon 1 of the murine 7.2b gene is 151 bp in length, contains the initiation of translation start site (ATG), and is flanked on the 3′ side by a 10.5-kb intron (Fig 1A).13 A murine (129 strain) P1 clone containing the entire 7.2b gene was used in the construction of a targeting vector designed to delete the putative 7.2b promoter, as well as the translation initiator ATG (Fig 1B). In addition to causing this 637-bp deletion, the targeting vector was designed to insert a human growth hormone polyA-signal/terminator and a neomycin gene expression cassette in place of the deleted region to increase the likelihood of completely shutting down 7.2b expression. The structure of the targeting event is shown in Fig 1C. After electroporation of ES cells, properly targeted clones were identified and injected into C57BL/6 blastocysts to generate chimeric mice. Germline transmission was obtained, and mice heterozygous for the targeting event were identified among these progeny. Heterozygotes were intercrossed to produce mice homozygous for the targeting event (Fig 1D). Homozygotes were normal in appearance, activity, and fertility.
Homologous recombination-mediated disruption of the 7.2b gene in mice. (A) Schematic representation of the 5′ region of the 7.2b gene including exon 1, intron 1, exon 2, and part of intron 2. B, BamHI sites. Shaded rectangles are the regions included in the targeting vector. (B) The 21-kb targeting vector. Neo, bacterial neomycin resistance gene; tk, herpes simplex virus thymidine kinase gene cassette; GHt, human growth hormone gene-N polyA-signal/terminator. (C) Structure of targeting event. 7.2KO-3 and 7.2KO-4, PCR primers used to screen for targeting event; probe A, probe used for genotyping by Southern analysis. (D) Genotyping mice by Southern blot analysis. BamHI cut genomic DNA probed with probe A. +/+, wild-type mice; +/−, mice heterozygous for 7.2b targeting event; −/−, mice homozygous for 7.2b targeting event. Size markers (kb) are from a 1-kb DNA ladder (GIBCO-BRL, Gaithersburg, MD).
Homologous recombination-mediated disruption of the 7.2b gene in mice. (A) Schematic representation of the 5′ region of the 7.2b gene including exon 1, intron 1, exon 2, and part of intron 2. B, BamHI sites. Shaded rectangles are the regions included in the targeting vector. (B) The 21-kb targeting vector. Neo, bacterial neomycin resistance gene; tk, herpes simplex virus thymidine kinase gene cassette; GHt, human growth hormone gene-N polyA-signal/terminator. (C) Structure of targeting event. 7.2KO-3 and 7.2KO-4, PCR primers used to screen for targeting event; probe A, probe used for genotyping by Southern analysis. (D) Genotyping mice by Southern blot analysis. BamHI cut genomic DNA probed with probe A. +/+, wild-type mice; +/−, mice heterozygous for 7.2b targeting event; −/−, mice homozygous for 7.2b targeting event. Size markers (kb) are from a 1-kb DNA ladder (GIBCO-BRL, Gaithersburg, MD).
Documentation of the Absence of Protein 7.2b in Knock-out Mouse RBCs
As shown in Fig 2, no immunoreactive protein 7.2b could be detected in knock-out mouse RBC membranes, using a rabbit polyclonal antihuman 7.2b antibody that readily detected 7.2b in normal human or murine RBC membranes. To confirm this finding, a monoclonal antimouse 7.2b antibody that reacts with the cytoplasmic tail of protein 7.2b was used. Protein 7.2b was readily detected in normal mouse RBCs, but not in knock-out RBCs. A cross-reacting protein at 66 kD was noted in both normal and 7.2b-deficient mouse RBCs.
SDS-PAGE of mouse RBC membrane proteins showing the absence of immunoreactive protein 7.2b in homozygous 7.2b knock-out mouse RBC. Lane 1, control mouse; lane 2, homozygous 7.2b knock-out mouse. (A) SDS-PAGE gel stained with coomassie blue. A 30-kD band is seen in both wild-type and 7.2b knock-out mouse samples, reflecting the presence of several non-7.2b RBC membrane proteins normally found in this region.2 (B) Immunoblot of SDS-PAGE gel prepared with affinity-purified rabbit polyclonal antihuman protein 7.2b antibody. (C) Immunoblot of SDS-PAGE gel prepared with monoclonal murine antimouse protein 7.2b antibody. Immunoreactive 7.2b is absent from the RBC membranes of the knock-out mouse.
SDS-PAGE of mouse RBC membrane proteins showing the absence of immunoreactive protein 7.2b in homozygous 7.2b knock-out mouse RBC. Lane 1, control mouse; lane 2, homozygous 7.2b knock-out mouse. (A) SDS-PAGE gel stained with coomassie blue. A 30-kD band is seen in both wild-type and 7.2b knock-out mouse samples, reflecting the presence of several non-7.2b RBC membrane proteins normally found in this region.2 (B) Immunoblot of SDS-PAGE gel prepared with affinity-purified rabbit polyclonal antihuman protein 7.2b antibody. (C) Immunoblot of SDS-PAGE gel prepared with monoclonal murine antimouse protein 7.2b antibody. Immunoreactive 7.2b is absent from the RBC membranes of the knock-out mouse.
RBC phenotype.
Mice lacking detectable protein 7.2b did not exhibit hemolytic anemia (Table 1). Their RBC morphology was normal and in particular, stomatocytes were absent (Fig 3). Ektacytometry curves for control and 7.2b knock-out mice are shown in Fig 4. The curves overlap, and no significant difference was found in the values of DImax, Omin, or Ohyp. Thus, the absence of protein 7.2b had no effect on the cellular deformability of the RBCs, indicating that the surface area to volume ratio, state of cellular hydration, and membrane mechanical properties are not changed as a result of the absence of this protein. In keeping with this finding, the RBC indices (mean corpuscular volume [MCV] and mean corpuscular hemoglobin concentration [MCHC]) were normal as was the RBC monovalent cation (Na+ and K+) content (Table 1). Thus, 7.2b-deficient mice did not exhibit the hereditary stomatocytosis phenotype seen in 7.2b-deficient humans.
Hematology and RBC Cation Content of 7.2b Knock-Out Mice
| . | 7.2b-Deficient Mice . | Control Mice . |
|---|---|---|
| Parameter | (Δ7.2b/Δ7.2b) | (+//+) |
| RBC cations | ||
| Na+(mmol/L RBC) | 5.1 ± 0.8 | 4.6 ± 0.6 |
| K+(mmol/L RBC) | 133.4 ± 4.0 | 132.3 ± 4.6 |
| Na+ + K+ (mmol/L RBC) | 138.5 ± 4.5 | 136.9 ± 4.6 |
| Hematology | ||
| Hematocrit (%) | 52.8 ± 1.0 | 51.4 ± 1.8 |
| Reticulocytes (%) | 2.4 ± 0.7 | 2.4 ± 0.7 |
| MCV (fL) | 43.0 ± 1.2 | 43.5 ± 0.9 |
| MCHC (g/dL) | 30.0 ± 0.8 | 30.3 ± 0.7 |
| . | 7.2b-Deficient Mice . | Control Mice . |
|---|---|---|
| Parameter | (Δ7.2b/Δ7.2b) | (+//+) |
| RBC cations | ||
| Na+(mmol/L RBC) | 5.1 ± 0.8 | 4.6 ± 0.6 |
| K+(mmol/L RBC) | 133.4 ± 4.0 | 132.3 ± 4.6 |
| Na+ + K+ (mmol/L RBC) | 138.5 ± 4.5 | 136.9 ± 4.6 |
| Hematology | ||
| Hematocrit (%) | 52.8 ± 1.0 | 51.4 ± 1.8 |
| Reticulocytes (%) | 2.4 ± 0.7 | 2.4 ± 0.7 |
| MCV (fL) | 43.0 ± 1.2 | 43.5 ± 0.9 |
| MCHC (g/dL) | 30.0 ± 0.8 | 30.3 ± 0.7 |
RBC cation determinations were performed on control (n = 4) and 7.2-deficient (n = 5) mice. Hematologic measurements were performed on control (n = 8) and 7.2b-deficient (n = 8) mice. Values shown are mean ± standard deviation. The 7.2b-deficient and control mice did not differ in any of the measured parameters (analyzed byt-test).
RBC morphology. (Top) RBCs from a 7.2b knock-out mouse. (Bottom) RBCs from a human hereditary stomatocytosis patient. A typical stomatocyte is indicated by the arrow. Note the absence of stomatocytes in the 7.2b knock-out mouse sample. Original magnification × 500.
RBC morphology. (Top) RBCs from a 7.2b knock-out mouse. (Bottom) RBCs from a human hereditary stomatocytosis patient. A typical stomatocyte is indicated by the arrow. Note the absence of stomatocytes in the 7.2b knock-out mouse sample. Original magnification × 500.
Osmotic gradient ektacytometry of normal mouse RBCs (○) and RBCs from heterozygous (□) or homozygous (◂) protein 7.2b knock-out mice. Two data sets from each genotype are shown. The positions of DImax, Omin, and Ohypfor the six samples are as indicated. No difference between the different types of RBCs was evident.
Osmotic gradient ektacytometry of normal mouse RBCs (○) and RBCs from heterozygous (□) or homozygous (◂) protein 7.2b knock-out mice. Two data sets from each genotype are shown. The positions of DImax, Omin, and Ohypfor the six samples are as indicated. No difference between the different types of RBCs was evident.
RBC membrane lipid translocation was also assessed in 7.2b-deficient and normal mice. Blood samples from C57 control mice and 7.2b-deficient mice were incubated in the presence or absence of fluorescent annexin V and analyzed using flow cytometry. A very small subpopulation of RBCs showed annexin V labeling in the the 7.2b-deficient RBCs (0.32% ± 0.12%), which was not significantly different from C57 control RBCs (0.39% ± 0.04%). These results indicate that in 7.2b-deficient mouse RBCs PS was not exposed and PS asymmetry was maintained. Treatment of RBCs with calcium ionophore A23187 in the presence of calcium will lead to an increase in cytosolic calcium and loss of phospholipid asymmetry as the result of a decrease in flipase activity and an increase in scramblase activity.29 When 7.2b-deficient and C57 control RBCs were incubated in the presence of 1 mmol/L calcium and 4 μmol/L A23187, no difference was found in the level of annexin V labeling (not shown), indicating that both types of RBCs exposed PS to the same degree as the result of calcium loading. Together these data suggest that flipase and scramblase activity is normal in 7.2b-deficient mouse RBCs, in accordance with the contention of Ho et al30 that the 7.2b protein has neither scramblase nor flipase activity.
DISCUSSION
The central finding of this report is that murine RBCs that lack membrane protein 7.2b do not exhibit the phenotype of hereditary stomatocytosis that is seen in human RBCs deficient in this protein. We interpret this to indicate that protein 7.2b does not play an important or direct role in cation transport. Its absence in human hereditary stomatocytosis may point to an abnormality in a partner binding protein necessary for the insertion and retention of 7.2b in the erythrocyte membrane. The abnormality in the partner binding protein rather than the lack of 7.2b then would be responsible for abnormal cation transport, stomatocytosis, and hemolytic anemia. Because there should be no alteration in the putative binding protein in the 7.2b-deficient mice we created, the stomatocyte phenotype would not be generated. There is precedence for this type of phenomenon in RBCs, namely the interaction between P55, protein 4.1, and glycophorin C. The complete deficiency of P55 observed in RBCs deficient in either protein 4.1 or glycophorin C has been taken to indicate that in the absence of either protein 4.1 or glycophorin C, P55 cannot associate with the RBC membrane.31 The identity of the 7.2b binding protein is purely speculative, because despite extensive biochemical investigation, little is known about interactions between protein 7.2b and neighboring erythrocyte membrane proteins. Because it is extremely difficult to solubilize, its associations and binding interactions with other membrane constituents remain largely undefined. Cross-linking studies suggest that it does not interact with cytoskeletal proteins,32 but detergent-prepared cytoskeletal preparations do contain immunoreactive protein 7.2b.5 A potential interaction between 7.2b and β-adducin, a membrane skeletal protein, has been suggested,33 but confirmation of this association has yet to be presented. Human erythrocyte protein 7.2b binds to a calpromotin affinity column, suggesting an association with this soluble cytoplasmic protein. This interaction is of interest because calpromotin is involved in the activation of the charybdotoxin-sensitive calcium-dependent potassium channel.34 A 40-kD human erythrocyte integral membrane protein, whose structure suggests that it may be a G protein-coupled receptor, has been isolated from human erythrocyte ghosts by affinity chromatography using a 14 amino acid polypeptide from the C-terminal cytoplasmic region of protein 7.2b. The function of this protein, which is widely distributed in different tissues, is not yet known and the nature of its interactions with protein 7.2b is yet to be defined.35 Finally, in a human epithelial cell line where protein 7.2b is upregulated by dexamethasone and interleukin-6 treatment, 7.2b colocalizes with cortical actin microfilaments indicating an association with the cytoskeleton.36 In this cell line, protein 7.2b self-associates to form homo-oligomers.37 Further work is needed to define the binding associations of 7.2b with itself and with neighbor proteins in erythrocytes.
It might be argued that our failure to observe the stomatocytosis phenotype in 7.2b-deficient mouse RBCs reflects a different role for this protein in mice and men. Although highly homologous, 7.2b protein structure is not identical in the two species. The serine-10 phosphorylation site present in the human polypeptide is absent in the mouse indicating that the mouse protein should not be phosphorylated.18 The 25 amino acids that comprise the murine 7.2b N-terminus have only a 31% to 32% degree of identity to the human equivalent. The 28 residue hydrophobic region that follows varies between the two species at four residues in its central region. The amino acid sequence of the large cytoplasmic C-terminus is 95% identical in the C57 mouse and human, not counting the four additional C-terminal amino acids present in the human protein.17However, it is unlikely that protein 7.2b function is distinctly different in mice and humans, as the function of other RBC proteins are highly conserved in the two species despite subtle differences in primary sequences.38-41
Several recent observations hint at a possible role for protein 7.2b in lipid translocation in erythrocyte membranes. Photoreactive phosphatidylethanolamine is preferentially incorporated into protein 7.2b leading Desneves et al42 to suggest that this protein could be a site of transbilayer reorientation of membrane phospholipids. A gene (unc-24) found in C elegansencodes a novel bipartite protein with regions of similarity to protein 7.2b and to nonspecific lipid transfer protein. Mutations in this protein impair normal locomotion and response to volatile anesthetics in the worm. These findings suggest that unc-24 may regulate membrane lipid transfer and/or an ion channel.43 On the other hand, Kuypers et al44 found the composition, distribution, and transbilayer kinetics of erythrocyte membrane phospholipids were normal in 7.2b-deficient human hereditary stomatocytes. In the experiments of Ho et al,30 human hereditary stomatocytosis RBCs, which completely lacked protein 7.2b, had normal transbilayer movement of labeled phosphatidylcholine (“flippase”) and normal “scramblase” activity as well, indicating that the major elements of phospholipid transbilayer movement were present. In the presence of vanadate, however, the transbilayer movement of phosphatidyl serine from outer to inner leaflet was faster than normal and from inner to outer leaflet slower than normal. The significance of this observation in the pathophysiology of hereditary stomatocytosis is unclear, but it might contribute to the stomatocytic shape change by fostering accumulation of phospholipid in the inner leaflet. We found no abnormalities of lipid translocation in 7.2b-deficient mouse RBCs and noted that these RBCs were discocytes, not stomatocytes. Thus, our observations do not support a role for protein 7.2b in lipid translocation.
Finally, it will be of interest to explore the function of protein 7.2b in nonerythroid tissues. The gene is widely expressed in human12,35 and murine17 tissues. This being the case, it is of interest that homozygous knock-out mice that completely lack erythrocyte protein 7.2b live to become apparently normal adults. Whether protein 7.2b is somehow expressed in nonerythroid tissues of these 7.2b-deficient animals or whether its functions can be subsumed by other proteins will be the subject of future investigation.
Supported by Grants No. DK 26263, DK 32094, HL 31579, and HL 55213 from the National Institutes of Health, Bethesda, MD.
Y.Z. and C.P. contributed equally to this project.
The publication costs of this article were defrayed in part by page charge payment. This article must therefore be hereby marked “advertisement” in accordance with 18 U.S.C. section 1734 solely to indicate this fact.
REFERENCES
Author notes
Address reprint requests to William C Mentzer, MD, Room 331, Bldg 100, San Francisco General Hospital, 1001 Potrero Ave, San Francisco, CA 94110; e-mail: wmentzer@sfghpeds.ucsf.edu.

This feature is available to Subscribers Only
Sign In or Create an Account Close Modal